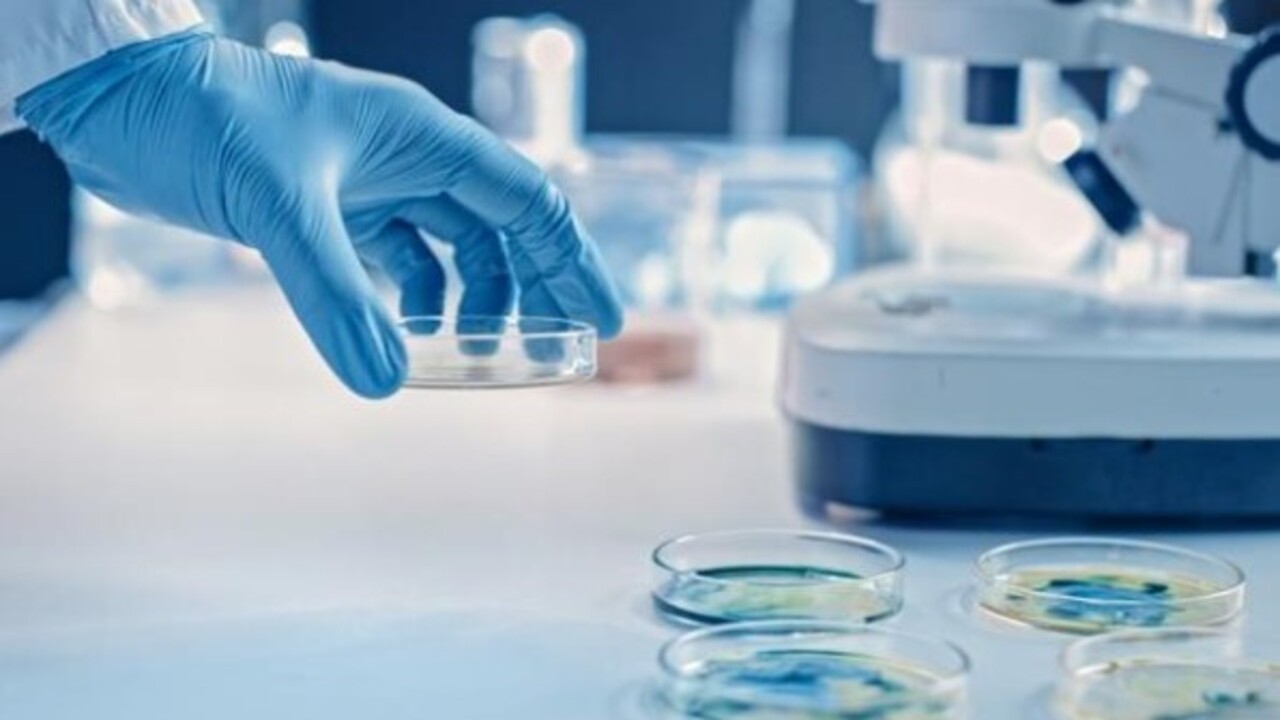
Foto - Ölümcül enfeksiyon uyarısı! O markanın şampuanları raflardan toplatılıyor

Ölümcül enfeksiyon uyarısı! O markanın şampuanları raflardan toplatılıyor
Geri çağırma duyurusunun ABD pazarını etkilediğini ifade eden uzmanlar, içerisinde 'klebsiella oxytoca' bulunan tek ürünün şampuan olmadığını öne sürüyor. İtalyan yetkililer, test ettikleri binden fazla inek peyniri ve salam örneğinin yüzde 6'sında klebsiella bakterisine rastladıklarını açıkladılar.